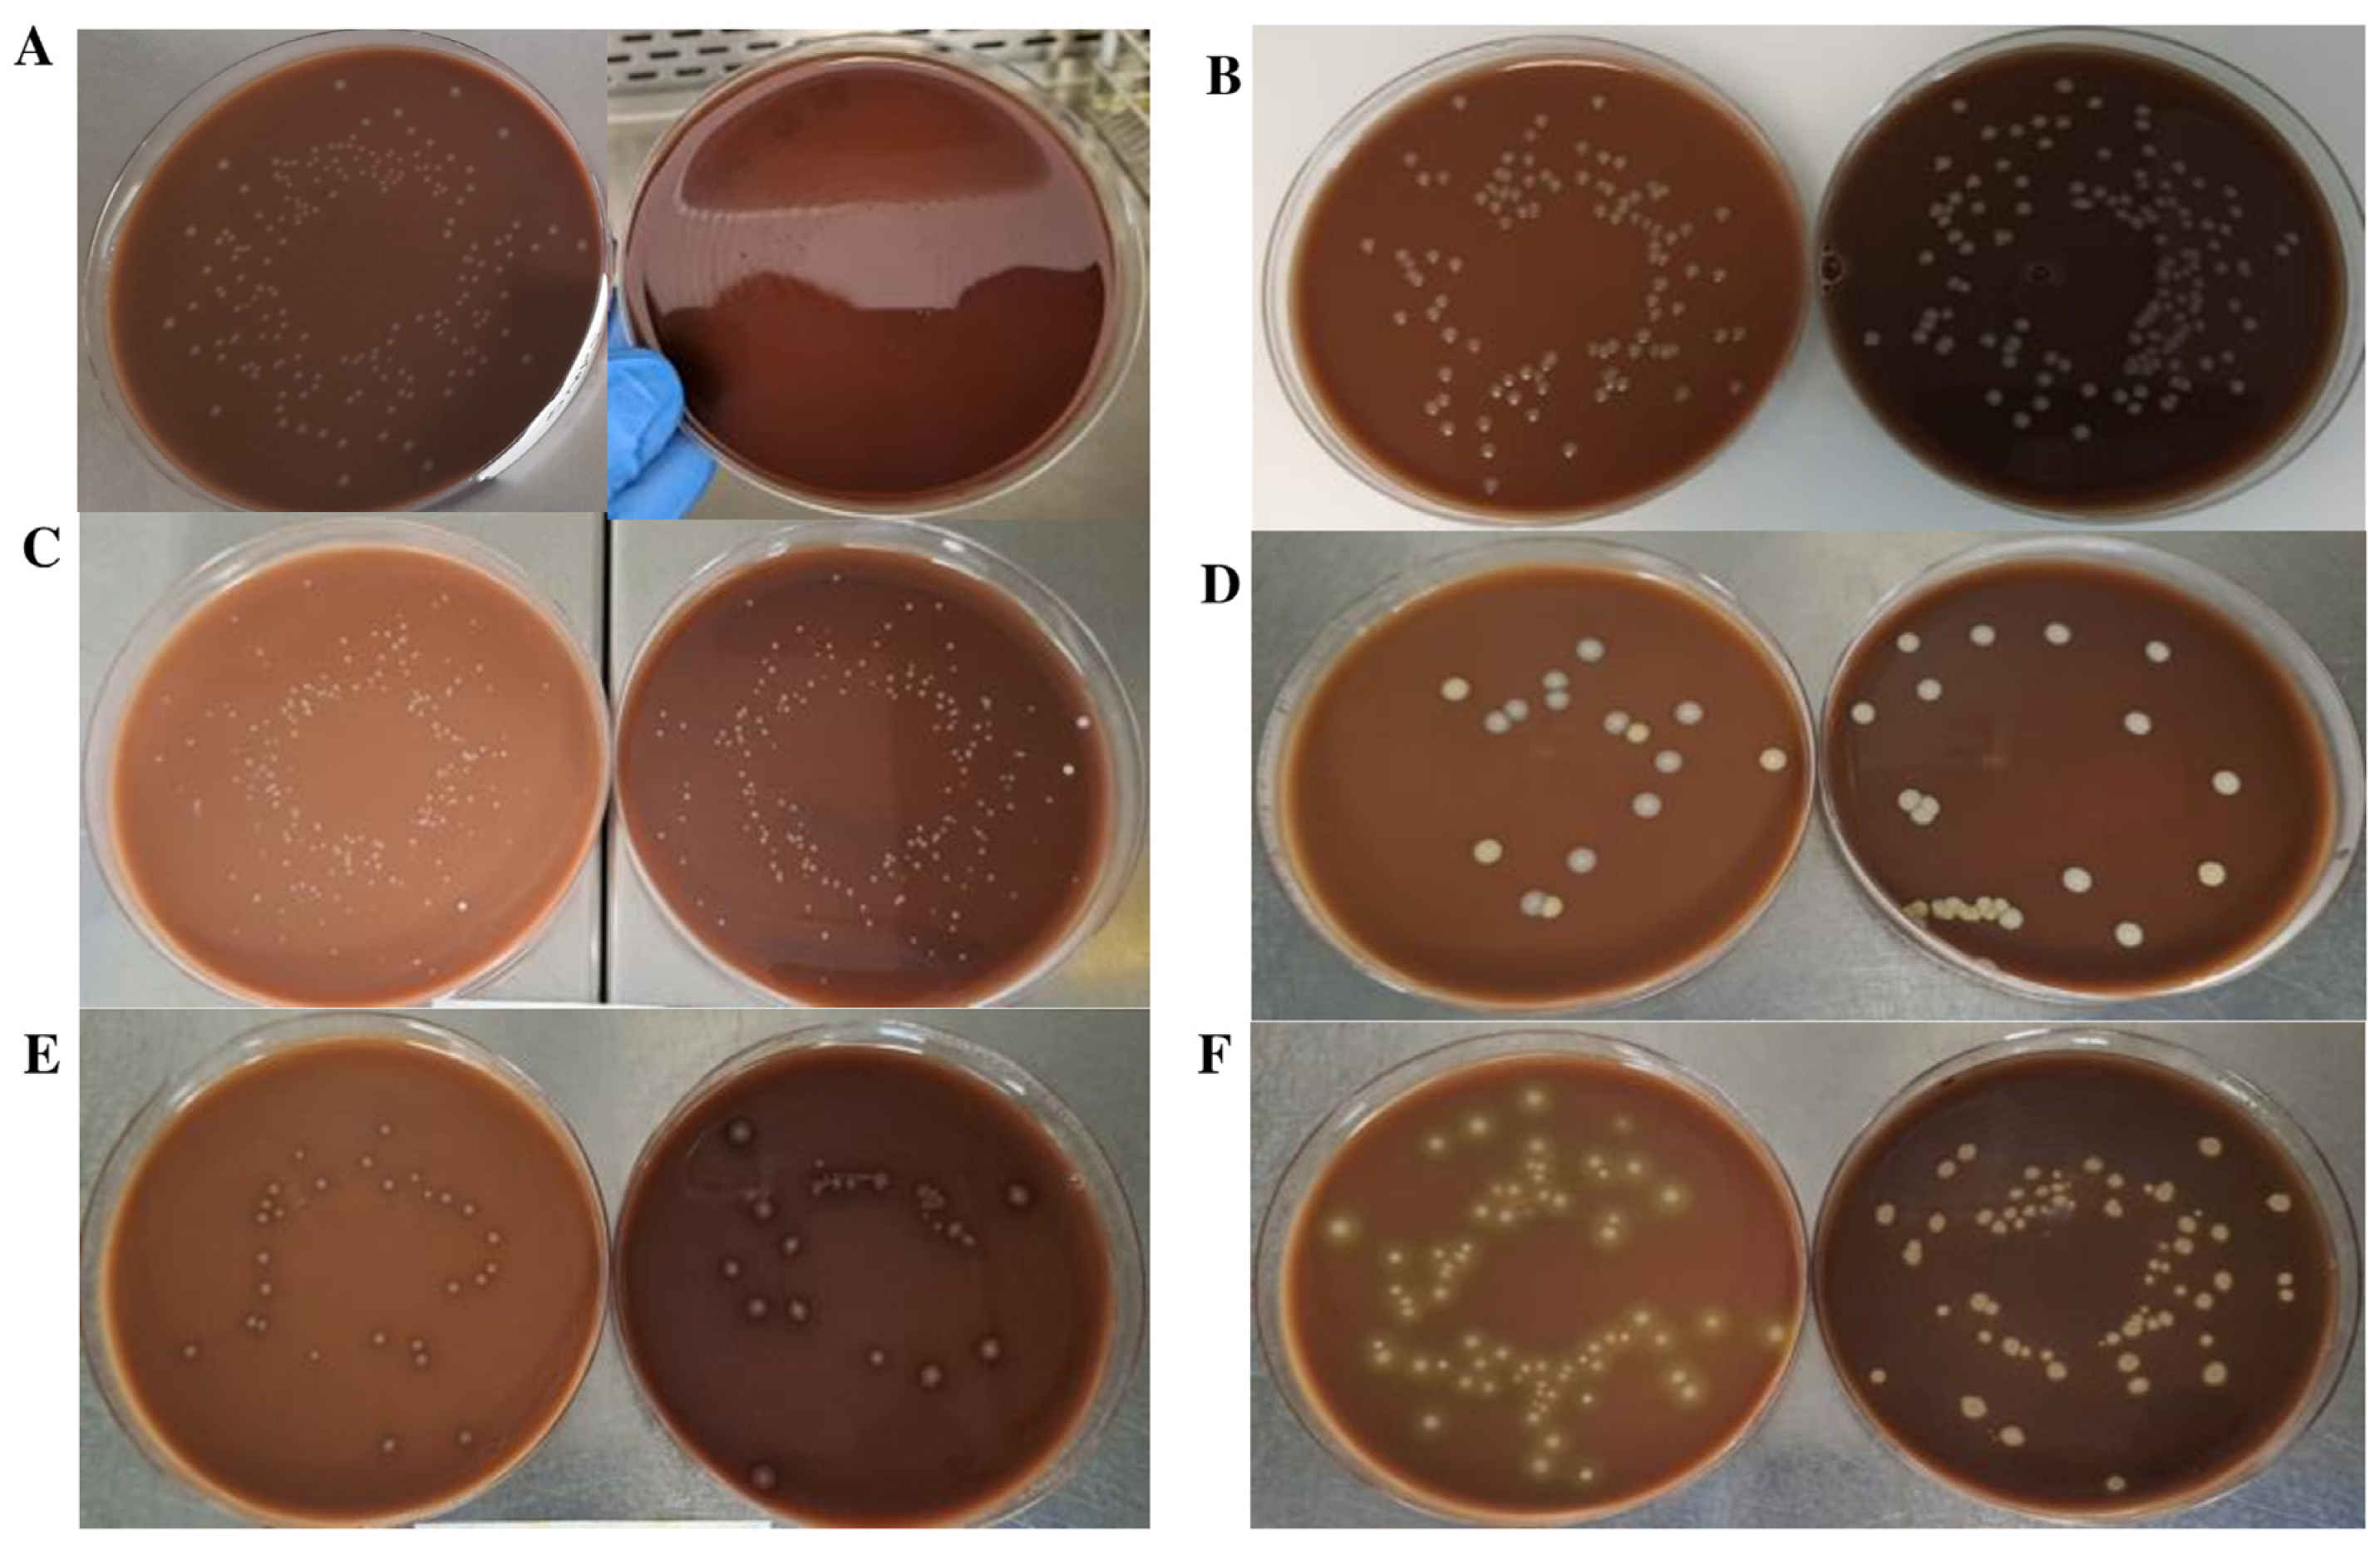
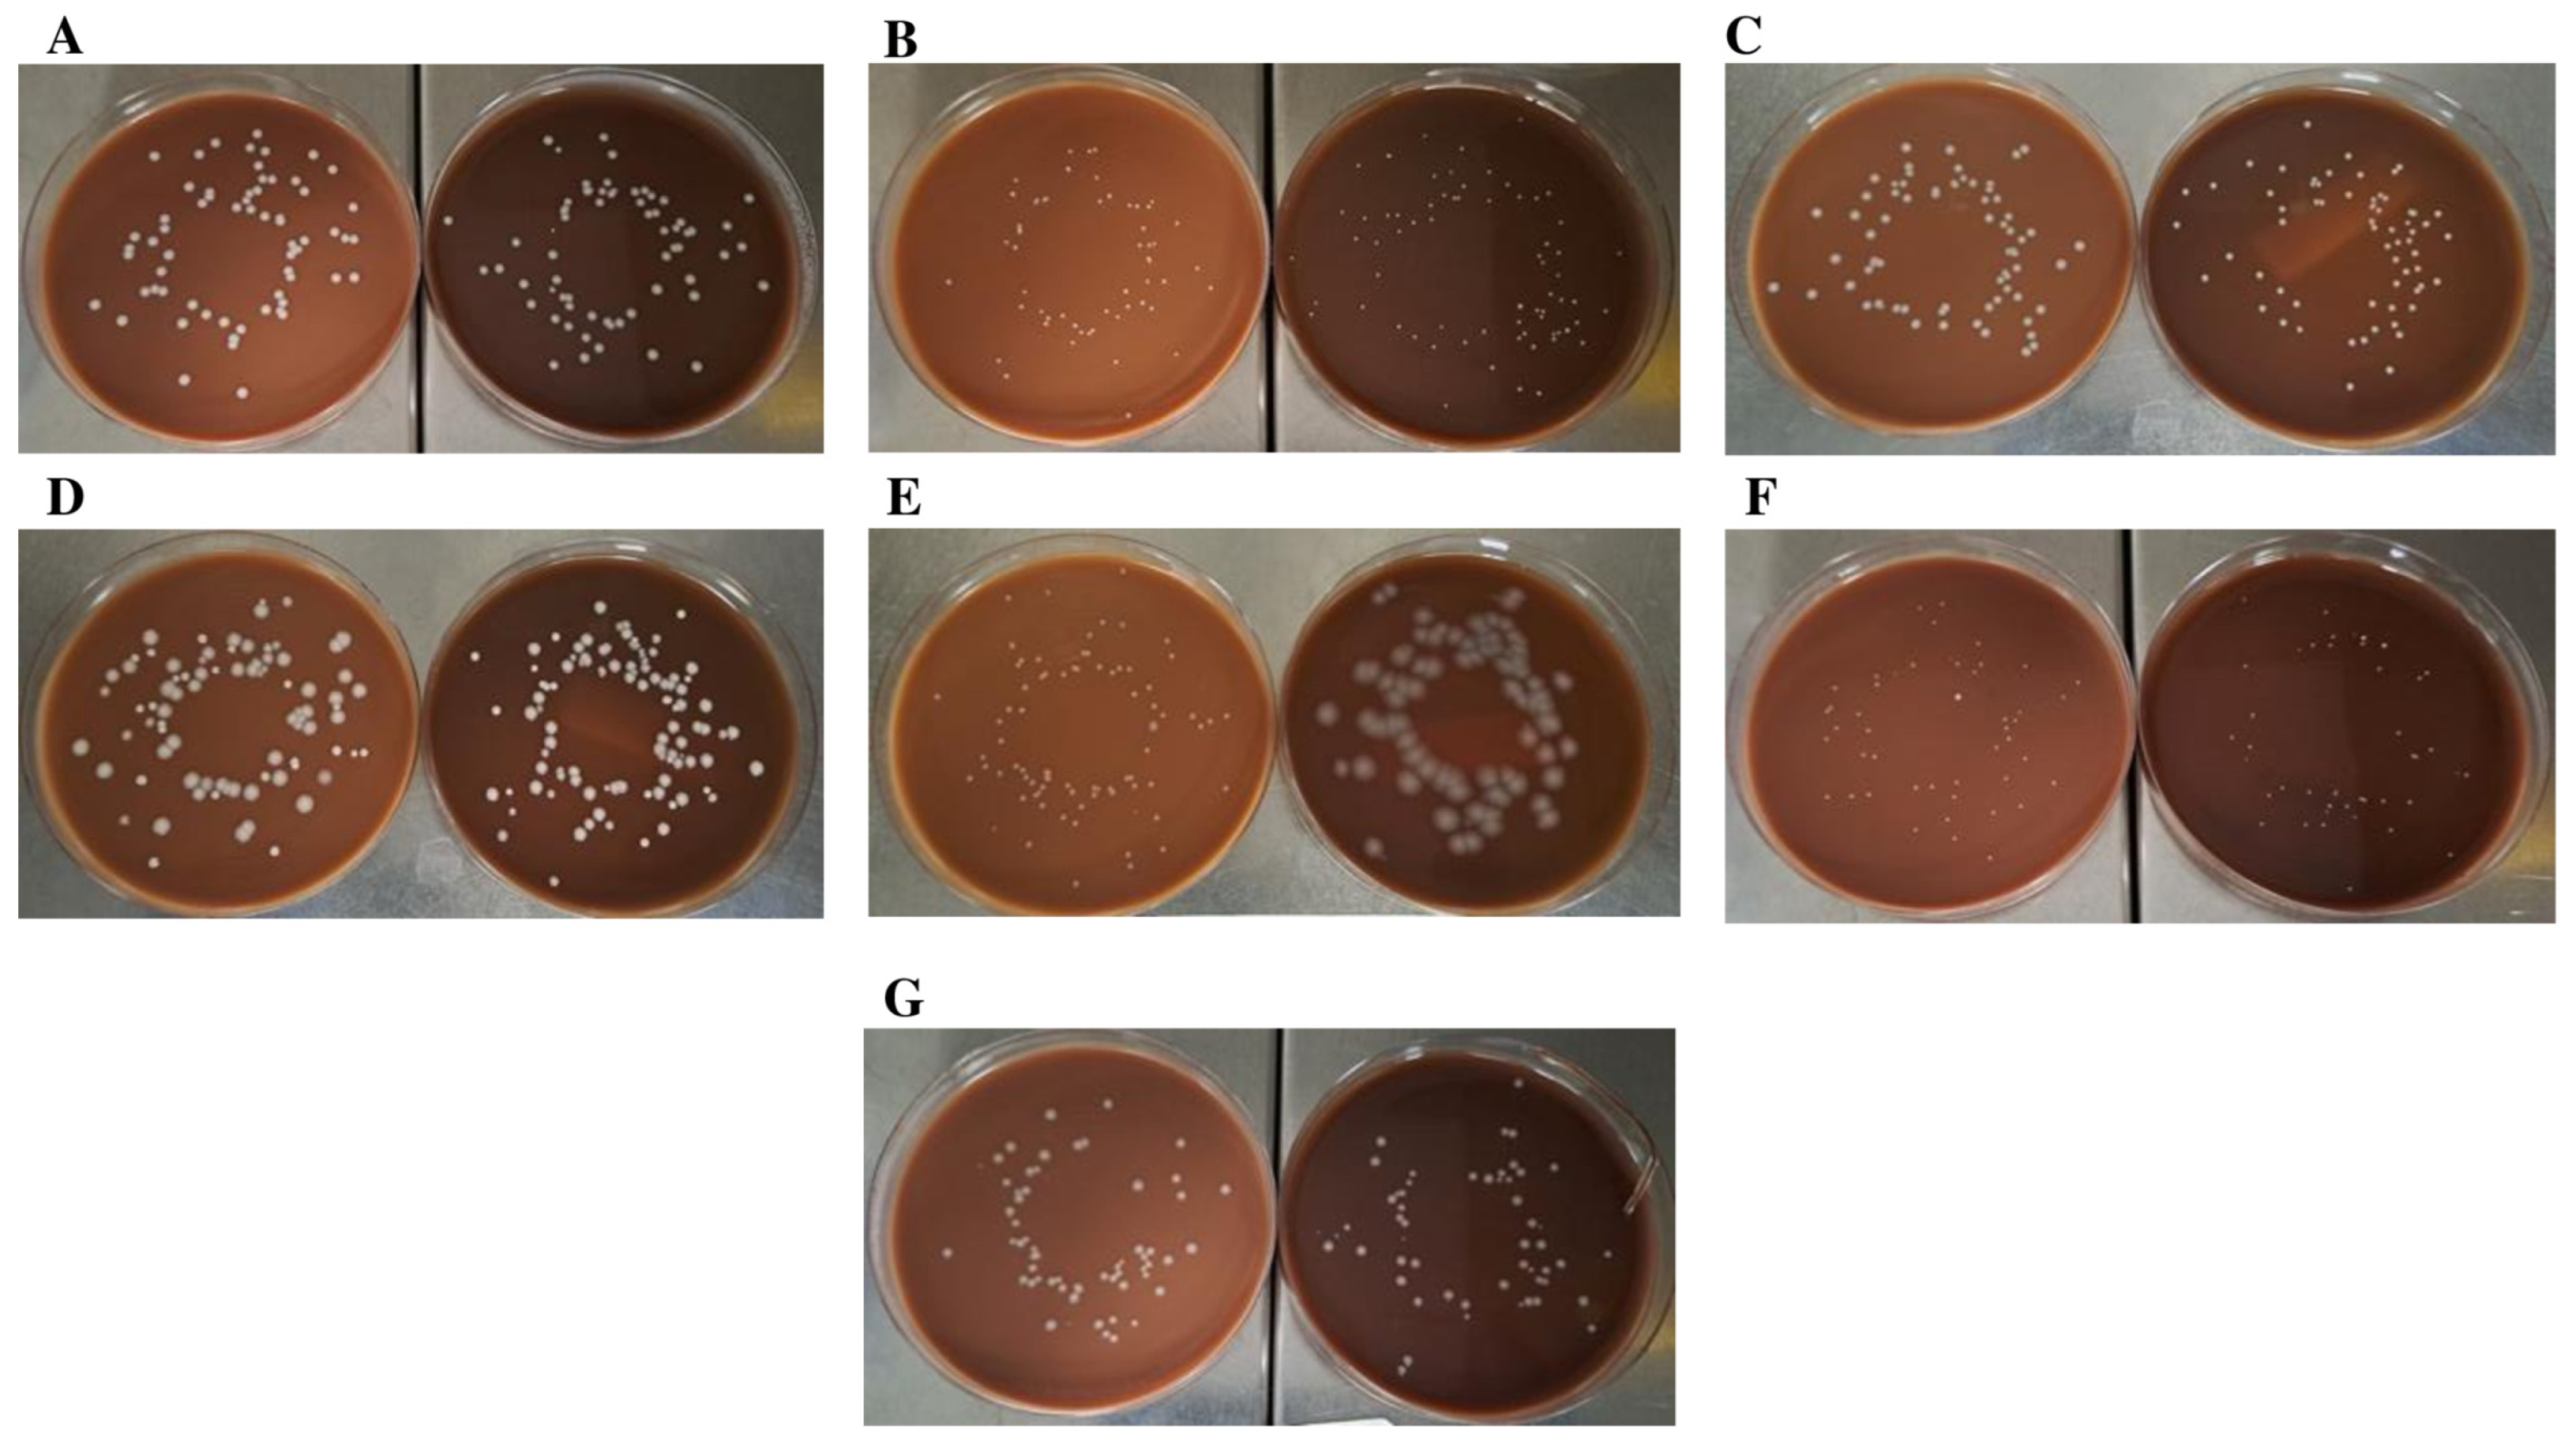

Use of Blood Powder (Ground and Irradiated) for the Manufacture of Chocolate Agar
Abstract
1. Introduction
2. Results
2.1. Comparison of Chocolate Agar Prepared with Autoclaved or Irradiated BP
2.2. Comparison of Microbiological and Physical Properties of Chocolate Agar Prepared with Ground and Irradiated BP vs. Conventional Chocolate Agar
3. Discussion
4. Material and Methods
4.1. Media Preparation
4.2. Inocula Preparation and Seeding
4.3. Colony Count
4.4. Statistical Analysis
Funding
Institutional Review Board Statement
Informed Consent Statement
Conflicts of Interest
Abbreviations
| Abbreviation | Complete phrase |
| BP | Blood powder |
| NAD | Nicotinamide adenine dinucleotide |
| Hb | Hemoglobin |
| CA | Conventional chocolate agar |
| CA-PR | Chocolate agar with blood powder treated with irradiation |
| CA-PT | Chocolate agar with blood powder treated with temperature |
| CA-BPR | Chocolate agar with blood powder treated with grinding and irradiation |
| GC | Gonococcus |
| GPS | Growth promotion supplement |
| ISO | International Organization for Standardization |
| spp. | Species |
| ATCC | American Type Culture Collection |
| CFU | Colony-forming unit |
| RBC | Red blood cells |
References
- Gratten, M.; Battistutta, D.; Torzillo, P.; Dixon, J.; Manning, K. Comparison of goat and horse blood as culture medium supplements for isolation and identification of Haemophilus influenzae and Streptococcus pneumoniae from upper respiratory tract secretions. J. Clin. Microbiol. 1994, 32, 2871–2872. [Google Scholar] [CrossRef] [PubMed]
- Podkopaev, Y.V.; Domotenko, L.V.; Morozova, T.P.; Khramov, M.K.; Shepelin, A.P. The national nutrient medium for diagnostic of purulent bacterial meningitis. Klin. Lab. Diagn. 2015, 60, 59–64. [Google Scholar] [PubMed]
- Froböse, N.J.; Idelevich, E.A.; Schaumburg, F. Short Incubation of Positive Blood Cultures on Solid Media for Species Identification by MALDI-TOF MS: Which Agar Is the Fastest? Microbiol. Spectr. 2021, 9, e0003821. [Google Scholar] [CrossRef] [PubMed]
- World Health Organization (WHO). Manual for Procurement of Diagnostics and Related Laboratory Items and Equipment. 2013. Available online: http://www.who.int/about/licensing/copyright_form/en/index.html (accessed on 1 January 2023).
- Chacón, A. Evaluación Sangre cordero. MJ. MEDISAN 25(3). 2021. Available online: www.medisan.sld.cu/index.php/san/rt/printerFriendly/3448/html (accessed on 1 January 2023).
- Gunn, B.A. Chocolate agar, a differential medium for gram-positive cocci. J. Clin. Microbiol. 1984, 20, 822–823. [Google Scholar] [CrossRef]
- Niederstebruch, N.; Sixt, D. Standard Nutrient Agar 1 as a substitute for blood-supplemented Müller–Hinton agar for antibiograms in developing countries. Eur. J. Clin. Microbiol. Infect. Dis. 2012, 32, 237–241. [Google Scholar] [CrossRef]
- Niederstebruch, N.; Sixt, D.; Benda, B.I.; Banboye, N. A suitable blood agar containing human blood especially for the use in laboratories of developing countries. J. Infect. Dev. Ctries. 2017, 11, 399–406. [Google Scholar] [CrossRef]
- Oktari, A.; Vanawati, N.; Kurniawati, U.I. The optimization of Human Blood Agar (HBA) for Streptococcus pneumonia growth. J. Phys. Conf. Ser. 2019, 1280, 022002. [Google Scholar] [CrossRef]
- Yeh, E.; Pinsky, B.A.; Banaei, N.; Baron, E.J. Hair Sheep Blood, Citrated or Defibrinated, Fulfills All Requirements of Blood Agar for Diagnostic Microbiology Laboratory Tests. PLoS ONE 2009, 4, e6141. [Google Scholar] [CrossRef]
- Magbojos, C.R. Preparation of the Blood-Enriched Agar with the Use of Red Cell Suspension. Asian J. Health 2011, 1, 259–275. [Google Scholar] [CrossRef]
- Phillips, C.A. The effect of citric acid, lactic acid, sodium citrate and sodium lactate, alone and in combination with nisin, on the growth of Arcobacter butzleri. Lett. Appl. Microbiol. 1999, 29, 424–428. [Google Scholar] [CrossRef]
- Young, K.M.; Foegeding, P.M. Acetic, lactic and citric acids and pH inhibition of Listeria monocytogenes Scott A and the effect on intracellular pH. J. Appl. Bacteriol. 1993, 74, 515–520. [Google Scholar] [PubMed]
- Russell, F.M.; Biribo, S.S.N.; Selvaraj, G.; Oppedisano, F.; Warren, S.; Seduadua, A.; Mulholland, E.K.; Carapetis, J.R. As a Bacterial Culture Medium, Citrated Sheep Blood Agar Is a Practical Alternative to Citrated Human Blood Agar in Laboratories of Developing Countries. J. Clin. Microbiol. 2006, 44, 3346–3351. [Google Scholar] [CrossRef] [PubMed]
- Carpenter, C.M.; Bucca, M.A.; Buck, T.C.; Gasman, E.P.; Christensen, C.W.; Crowe, E.; Drew, R.; Hill, J.; Lankford, C.E.; Morton, H.E.; et al. Evaluation of Twelve Media for the Isolation of the Gonoeoccus. Am. J. Syph. 1949, 33, 164–176. [Google Scholar] [PubMed]
- Evans, N.M.; Smith, D.D.; Wicken, A.J. Haemin and Nicotinamide Adenine Dinucleotide Requirements of Haemophilus influenzae and Haemophilus parainfluenzae. J. Med. Microbiol. 1974, 7, 359–365. [Google Scholar] [CrossRef] [PubMed]
- Tankeshwar, A. Chocolate agar: Composition, uses and colony characteristics. Microbeonline 2013, 36–37. Available online: https://microbeonline.com/chocolate-agar-composition-uses-colony-characteristics/ (accessed on 1 January 2023).
- Anderson, P.J.; Biro, G.P. A convenient Method for the Determination of the Solubility of Hemoglobin and Modified Hemoglobins. Artif. Cells Blood Substit. Biotechnol. 1994, 22, 753–761. [Google Scholar] [CrossRef]
- Jacob, H.S.; Brain, M.C.; Dacie, J.V.; Carrell, R.W.; Lehmann, H. Abnormal Haem Binding and Globin SH Group Blockade in Unstable Haemoglobins. Nature 1968, 218, 1214–1217. [Google Scholar] [CrossRef]
- Lehmann, H.; Carrell, R.W. Variations in the structure of human haemoglobin with Particular Reference to the Unstable Haemoglobins. Br. Med. Bull. 1969, 25, 14–23. [Google Scholar] [CrossRef]
- Rieder, R.F. Hemoglobin stability: Observations on the denaturation of normal and abnormal hemoglobins by oxidant dyes, heat, and alkali. J. Clin. Investig. 1970, 49, 2369–2376. [Google Scholar] [CrossRef]
- Beski, S.S.M.; Swick, R.A.; Iji, P.A. Specialized protein products in broiler chicken nutrition: A review. Anim. Nutr. 2015, 1, 47–53. [Google Scholar] [CrossRef]
- Najjari, F.; Ghasemi, S. Changes in chemical properties of sawdust and blood powder mixture during vermicomposting and the effects on the growth and chemical composition of cucumber. Sci. Hortic. 2018, 232, 250–255. [Google Scholar] [CrossRef]
- Dipanjali, K.; Barman, K. Potential of utilization of animal by-products in animal feed. North-East Vet. 2005, 5, 28–31. Available online: https://www.cabdirect.org/cabdirect/abstract/20063050581 (accessed on 1 January 2023).
- Hasanain, F.; Guenther, K.; Mullett, W.M.; Craven, E. Gamma Sterilization of Pharmaceuticals—A Review of the Irradiation of Excipients, Active Pharmaceutical Ingredients, and Final Drug Product Formulations. PDA J. Pharm. Sci. Technol. 2014, 68, 113–137. [Google Scholar] [CrossRef] [PubMed]
- Park, S.-J.; Uyama, H.; Kwak, M.-S.; Sung, M.-H. Comparison of the Stability of Poly-γ-Glutamate Hydrogels Prepared by UV and γ-Ray Irradiation. J. Microbiol. Biotechnol. 2019, 29, 1078–1082. [Google Scholar] [CrossRef] [PubMed]
- Sung, W.-C. Effect of gamma irradiation on rice and its food products. Radiat. Phys. Chem. 2005, 73, 224–228. [Google Scholar] [CrossRef]
- Maghraby, A.M.; Ali, M.A. Spectroscopic study of gamma irradiated bovine hemoglobin. Radiat. Phys. Chem. 2007, 76, 1600–1605. [Google Scholar] [CrossRef]
- Vieira, C.L.; Garshick, E.; Alvares, D.; Schwartz, J.; Huang, S.; Vokonas, P.; Gold, D.R.; Koutrakis, P. Association between ambient beta particle radioactivity and lower hemoglobin concentrations in a cohort of elderly men. Environ. Int. 2020, 139, 105735. [Google Scholar] [CrossRef]
- Rodríguez, N.J.C.; Martinez, S. TEICHMANN prueba confirmativa para identificación de sangre en manchas. Sci. Tech. 2020, 25, 158–163. [Google Scholar] [CrossRef]
- Vaneechoutte, M.; Nemec, A.; Kämpfer, P.; Cools, P.; Wauters, G. Acinetobacter, Chryseobacterium, Moraxella, and Other Nonfermentative Gram-Negative Rods. In Manual of Clinical Microbiology, 10th ed.; Versalovic, J., Carroll, K.C., Funke, G., Jorgensen, J.H., Landry, M.L., Warnock, D.W., Eds.; ASM Press: Washington, DC, USA, 2015; pp. 813–837. [Google Scholar] [CrossRef]
- Barbé, G.; Babolat, M.; Boeufgras, J.M.; Monget, D.; Freney, J. Evaluation of API NH, a new 2-hour system for identification of Neisseria and Haemophilus species and Moraxella catarrhalis in a routine clinical laboratory. J. Clin. Microbiol. 1994, 32, 187–189. [Google Scholar] [CrossRef]
- Razali, K.; Kaidi, R.; Abdelli, A.; Menoueri, M.N.; Ait-Oudhia, K. Oral flora of stray dogs and cats in Algeria: Pasteurella and other zoonotic bacteria. Vet. World 2020, 13, 2806–2814. [Google Scholar] [CrossRef]
- Richardson, N.J.; Koornhof, H.J.; Bokkenheuser, V.D. Primary isolation of Campylobacter fetus subspecies jejuni. Am. J. Med. Technol. 1982, 48, 197–199. [Google Scholar] [PubMed]
- Young, K.T.; Davis, L.M.; DiRita, V.J. Campylobacter jejuni: Molecular biology and pathogenesis. Nat. Rev. Genet. 2007, 5, 665–679. [Google Scholar] [CrossRef] [PubMed]
- Marturano, J.E.; Lowery, T.J. ESKAPE Pathogens in Bloodstream Infections Are Associated with Higher Cost and Mortality but Can Be Predicted Using Diagnoses upon Admission. Open Forum Infect. Dis. 2019, 6, ofz503. [Google Scholar] [CrossRef] [PubMed]
- Mulani, M.S.; Kamble, E.E.; Kumkar, S.N.; Tawre, M.S.; Pardesi, K.R. Emerging Strategies to Combat ESKAPE Pathogens in the Era of Antimicrobial Resistance: A Review. Front. Microbiol. 2019, 10, 539. [Google Scholar] [CrossRef] [PubMed]
- Høiby, N.; Bjarnsholt, T.; Givskov, M.; Molin, S.; Ciofu, O. Antibiotic resistance of bacterial biofilms. Int. J. Antimicrob. Agents 2010, 35, 322–332. [Google Scholar] [CrossRef]
- Rogers, K.L.; Fey, P.D.; Rupp, M.E. Coagulase-Negative Staphylococcal Infections. Infect. Dis. Clin. North Am. 2009, 23, 73–98. [Google Scholar] [CrossRef]
- King, T.L.; Schmidt, S.; Essack, S.Y. Antibiotic resistant Klebsiella spp. from a hospital, hospital effluents and wastewater treatment plants in the uMgungundlovu District, KwaZulu-Natal, South Africa. Sci. Total Environ. 2019, 712, 135550. [Google Scholar] [CrossRef]
- Osman, E.A.; El-Amin, N.E.; Al-Hassan, L.L.; Mukhtar, M. Multiclonal spread of Klebsiella pneumoniae across hospitals in Khartoum, Sudan. J. Glob. Antimicrob. Resist. 2020, 24, 241–245. [Google Scholar] [CrossRef]
- Pöntinen, A.K.; Top, J.; Arredondo-Alonso, S.; Tonkin-Hill, G.; Freitas, A.R.; Novais, C.; Gladstone, R.A.; Pesonen, M.; Meneses, R.; Pesonen, H.; et al. Apparent nosocomial adaptation of Enterococcus faecalis predates the modern hospital era. Nat. Commun. 2021, 12, 1523. [Google Scholar] [CrossRef]
- ISO 11133:2014/AMD 1:2018; Microbiology of Food, Animal Feeding Stuffs and Water—Preparation, Production, Storage and Performance Testing of Culture Media. Swedish Standard: Stockholm, Sweden, 2018.
- ISO/IEC 17025:2017; General Requirements for the Competence of Testing and Calibration Laboratories. Asociación Española de Normalización: Madrid, Spain, 2017.
- Atlas, R.M. Handbook of Microbiological Media; CRC Press: Boca Raton, FL, USA, 2010. [Google Scholar]
- Clinical and Laboratory Standards Institute (CLSI). Performance Standards for Antimicrobial Susceptibility Testing: 8th Informational Supplement 28; CLSI: Wayne, PA, USA, 2008. [Google Scholar]

| Ingredient | Chocolate Agar (CA) g/L | Chocolate Agar with BP (CA-PR/CA-PT/CA-BPR) g/L |
|---|---|---|
| Special peptone | 15 | 15 |
| Yeast extract | 10 | 10 |
| Starch | 1 | 1 |
| Dextrose | 1.5 | 1.5 |
| Sodium chloride | 5 | 5 |
| Sodium bicarbonate | 0.15 | 0.15 |
| Potassium phosphate | 1 | 1 |
| Dipotassium phosphate | 4 | 4 |
| Agar | 12 | 12 |
| Growth Promotion Supplement * (NAD, L-cystine, cysteine, adenine, vitamin B1, vitamin B12, L-glutamine, guanine, p-aminobenzoic acid, cocarboxilase, ferric nitrate and glucose) | 2.75 | 2.75 |
| Blood powder * | 0 | 10 |
| Defibrinated ovine blood * | 50 mL | 0 |
| List of Microorganisms | ATCC ID | Atmospheric Conditions |
|---|---|---|
| Neisseria meningitidis | 13090 | 3.5–9% CO2 |
| Neisseria gonorrhoeae | 19424 | 3.5–9% CO2 |
| Haemophilus influenzae | 10211 | 3.5–9% CO2 |
| Campylobacter jejuni | 29428 | 2.5–9.5 % CO2 |
| Streptococcus pyogenes | 19615 | 3.5–9% CO2 |
| Streptococcus pneumoniae | 49619 | 3.5–9% CO2 |
| Staphylococcus aureus | 25923 | Aerobiosis |
| Staphylococcus epidermidis | 12228 | Aerobiosis |
| Enterococcus faecalis | 19433 | Aerobiosis |
| Klebsiella pneumoniae | 13883 | Aerobiosis |
| Pseudomonas aeruginosa | 9027 | Aerobiosis |
| Pasteurella multocida | 43137 | Aerobiosis |
| Moraxella catarrhalis | 25238 | Aerobiosis |
Disclaimer/Publisher’s Note: The statements, opinions and data contained in all publications are solely those of the individual author(s) and contributor(s) and not of MDPI and/or the editor(s). MDPI and/or the editor(s) disclaim responsibility for any injury to people or property resulting from any ideas, methods, instructions or products referred to in the content. |
© 2023 by the authors. Licensee MDPI, Basel, Switzerland. This article is an open access article distributed under the terms and conditions of the Creative Commons Attribution (CC BY) license (https://creativecommons.org/licenses/by/4.0/).
Share and Cite
Casino, P.; López, A.; Peiró, S.; Terrones, I.; Agustí, G.; Terlevich, D.; Asensio, D.; Marqués, A.M.; Piqué, N. Use of Blood Powder (Ground and Irradiated) for the Manufacture of Chocolate Agar. Int. J. Mol. Sci. 2023, 24, 7965. https://doi.org/10.3390/ijms24097965
Casino P, López A, Peiró S, Terrones I, Agustí G, Terlevich D, Asensio D, Marqués AM, Piqué N. Use of Blood Powder (Ground and Irradiated) for the Manufacture of Chocolate Agar. International Journal of Molecular Sciences. 2023; 24(9):7965. https://doi.org/10.3390/ijms24097965
Chicago/Turabian StyleCasino, Pablo, Asunción López, Sara Peiró, Inés Terrones, Gemma Agustí, Daniela Terlevich, Daniel Asensio, Ana María Marqués, and Núria Piqué. 2023. "Use of Blood Powder (Ground and Irradiated) for the Manufacture of Chocolate Agar" International Journal of Molecular Sciences 24, no. 9: 7965. https://doi.org/10.3390/ijms24097965
APA StyleCasino, P., López, A., Peiró, S., Terrones, I., Agustí, G., Terlevich, D., Asensio, D., Marqués, A. M., & Piqué, N. (2023). Use of Blood Powder (Ground and Irradiated) for the Manufacture of Chocolate Agar. International Journal of Molecular Sciences, 24(9), 7965. https://doi.org/10.3390/ijms24097965

